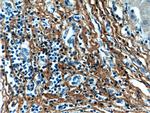
Fibromodulin Antibody in Immunohistochemistry (Paraffin) (IHC (P))

Search
Proteintech
Fibromodulin Monoclonal Antibody (3E9D10)
{{$productOrderCtrl.translations['antibody.pdp.commerceCard.promotion.promotions']}}
{{$productOrderCtrl.translations['antibody.pdp.commerceCard.promotion.viewpromo']}}
{{$productOrderCtrl.translations['antibody.pdp.commerceCard.promotion.promocode']}}: {{promo.promoCode}} {{promo.promoTitle}} {{promo.promoDescription}}. {{$productOrderCtrl.translations['antibody.pdp.commerceCard.promotion.learnmore']}}
产品信息
60108-1-IG
种属反应
已发表种属
宿主/亚型
分类
类型
克隆号
抗原
偶联物
形式
浓度
规格
纯化类型
保存液
内含物
保存条件
运输条件
产品详细信息
Immunogen sequence: MQWTSLLLL AGLFSLSQAQ YEDDPHWWFH YLRSQQSTYY DPYDPYPYET YEPYPYGVDE GPAYTYGSPS PPDPRDCPQE CDCPPNFPTA MYCDNRNLKY LPFVPSRMKY VYFQNNQITS IQEGVFDNAT GLLWIALHGN QITSDKVGRK VFSKLRHLER LYLDHNNLTR MPGPLPRSLR ELHLDHNQIS RVPNNALEGL ENLTALYLQH NEIQEVGSSM RGLRSLILLD LSYNHLRKVP DGLPSALEQL YMEHNNVYTV PDSYFRGAPK LLYVRLSHNS LTNNGLASNT FNSSSLLELD LSYNQLQKIP PVNTNLENLY LQGNRINEFS ISSFCTVVDV VNFSKLQVLR LDGNEIKRSA MPADAPLCLR LASLIEI (1-376 aa encoded by BC035281)
靶标信息
Fibromodulin is a member of a family of small interstitial proteoglycans, containing a central region composed of leucine-rich repeats with 4 keratan sulfate chains flanked by disulfide-bonded terminal domains. It may participate in the assembly of the extracellular matrix as it interacts with type I and type II collagen fibrils and inhibits fibrillogenesis in vitro. It may also regulate TGF-beta activities by sequestering TGF-beta into the extracellular matrix.
仅用于科研。不用于诊断过程。未经明确授权不得转售。
生物信息学
蛋白别名: Collagen-binding 59 kDa protein; epididymis secretory sperm binding protein; Fibromodulin; FM; Keratan sulfate proteoglycan fibromodulin; KSPG fibromodulin; unnamed protein product
基因别名: FM; FMOD; SLRR2E
UniProt ID: (Human) Q06828
Entrez Gene ID: (Human) 2331